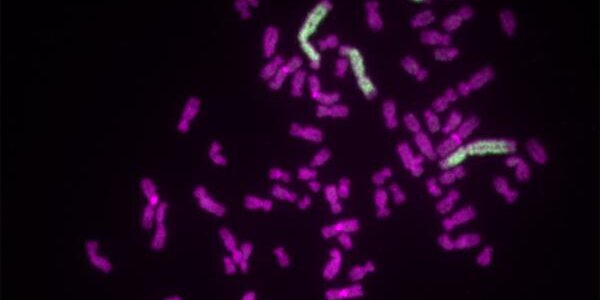
Article teaser image

Little Benefit, But Older Breast Cancer Patients Still Get Radiation
Women over the age of 70 with certain early-stage breast cancers don't get much benefit from radiation therapy, according to studies, but they still get it. The reason is because doctors were able to make decisions that overruled the published evidence and every patient wanted to take no chances.
Now, with government increasingly controlling health care in the United States, the search is one for ways to lessen such "defensive medicine" and cut costs. The problem is that it will be difficult to tell doctors and patients they won't get what was previously considered standard care under a…